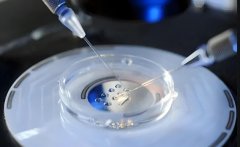
hcg是什么意思?hCG对照表对于试管移植有什么作用?

胚胎移植

-
 试管着床稳定期的影响因素是什么?着床稳定期要注意什么?
试管着床稳定期的影响因素是什么?着床稳定期要注意什么?试管鲜胚移植是一种备受欢迎的试管技术,能够在一定程度上帮助伴有不孕不育症的夫妻实现其生育梦想。一般来说试管鲜胚移植的着床稳定期是6-10天,也就是说,在这个期间,移植的胚
作者:兰兰 86 发布时间:2024-06-22 -
 注射亮丙瑞林多久后进行移植?移植需要注意什么会提高成功的可能?
注射亮丙瑞林多久后进行移植?移植需要注意什么会提高成功的可能?很多人都知道,器官移植是一种可能拯救生命的有效方法,但它也存在着一些问题,比如排斥反应、无偿提供器官的稀缺等,而近期通过注射亮丙瑞林28天后移植的方法可能会打破这些困境。
作者:兰兰 159 发布时间:2024-06-22 -
 试管宝贝悄然来袭!怀孕迹象大盘点,拉肚子或成报喜信号?
试管宝贝悄然来袭!怀孕迹象大盘点,拉肚子或成报喜信号?怀孕是每个女性健康发展的重要阶段,也是每个备孕家庭的重要环节。在怀孕初期,很多女性都会出现一些不规则的症状,其中有些症状可能会提示出怀孕的可能性,比如移植后拉肚子。那么
作者:wednesday 170 发布时间:2024-06-21 -
 胚胎宝宝“搬家”啦!移植后的小憩时间,你知道吗?
胚胎宝宝“搬家”啦!移植后的小憩时间,你知道吗?胚胎移植是一种治疗失败性不孕症的生育技术,它能够让夫妇拥有自己的孩子,实现夫妻梦想。然而,胚胎移植后,如何保护自己以及控制健康状况,是很重要的一环。因此本文将主要介绍胚
作者:wednesday 126 发布时间:2024-06-21 -
hcg是什么意思?hCG对照表对于试管移植有什么作用?
hcg是什么意思?hCG对照表对于试管移植有什么作用?试管移植是一种技术,可以帮助伴随不孕症的夫妻达到受孕的目的。人类孕酮(hCG)是一种激素,是辅助试管移植的关键因素。本文将详细介绍试管移植hCG对照表,为不孕症患者提供更多的参考。
作者:兰兰 169 发布时间:2024-06-21 -
 胚胎移植后反应大是怎么回事?胚胎移植后反应大正常吗?
胚胎移植后反应大是怎么回事?胚胎移植后反应大正常吗?移植后反应是指胎儿在植入子宫后的反应,它是胎儿生长发育的重要指标,也是保证胎儿健康发育的重要保障。一般来说,如果胎儿的移植后反应大,说明孕妇体内的各种条件非常适宜,为胎
作者:兰兰 157 发布时间:2024-06-21 -
 囊胚和鲜胚有什么区别?成功率是一样的吗?
囊胚和鲜胚有什么区别?成功率是一样的吗?囊胚和鲜胚是发育中的植物胚,它们在植物生殖中起着重要的作用,因此受到生物学家的广泛关注。它们之间存在一些差异,本文将详细介绍这两者的不同之处。 囊胚和鲜胚的区别 从形态结构
作者:盼盼 163 发布时间:2024-06-20 -
 5CA囊胚质量可观,冷冻移植同样孕育希望
5CA囊胚质量可观,冷冻移植同样孕育希望在辅助生殖技术中,囊胚的质量评估是预测移植成功率的关键因素之一。虽然5CA级别的囊胚在某些标准下可能被认为是质量较低,但实际上,它的质量并没有人们想象中那么差。因此,对于那
作者:多米 199 发布时间:2024-06-20 -
 女性囊胚移植5天成功着床了吗,根据身体情况分析
女性囊胚移植5天成功着床了吗,根据身体情况分析囊胚移植后着床时间受多种因素影响。首先,年龄是一个重要因素,年轻女性通常着床时间更短。其次,子宫内膜的厚度和质量也对着床起到关键作用。荷尔蒙水平的平衡以及个人的生活方式
作者:雨诗 135 发布时间:2024-06-20 -
 囊胚质量6CB成功率比较低,还能成功移植吗
囊胚质量6CB成功率比较低,还能成功移植吗6cb囊胚在移植过程中的成功率和质量都属于一般水平,但并非没有可能成功。对于想要进行移植的患者来说,这意味着成功的机会仍然存在,尽管需要考虑一些因素。囊胚的质量对移植成功至
作者:雨诗 50 发布时间:2024-06-20 -
 内膜异位做胚胎移植可不可行?这篇文章可以了解一下
内膜异位做胚胎移植可不可行?这篇文章可以了解一下子宫内膜异位症患者在经过适当的治疗和评估后,确实是可以考虑进行试管技术的。这一技术为那些因子宫内膜异位症而难以自然受孕的夫妇提供了新的希望。然而,试管技术并非适
作者:雨诗 160 发布时间:2024-06-20 -
 移植前的检查有哪些呢?这些检查一个都不能少
移植前的检查有哪些呢?这些检查一个都不能少现如今,许多夫妻希望能通过取卵后移植来实现梦想中的家庭规划,但是要完成取卵后移植,患者需要做一系列健康检查,以确保安全有效地实现该过程。本文将就取卵后移植前要做哪些检查
作者:兰兰 84 发布时间:2024-06-19
